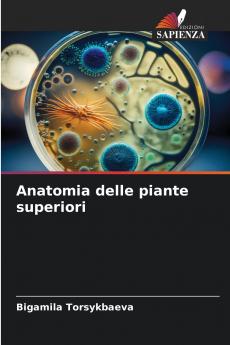
Anatomia delle piante superiori

Italian
Paperback
₹9731
₹12227
20.41% OFF
(All inclusive*)
Delivery Options
Please enter pincode to check delivery time.
*COD & Shipping Charges may apply on certain items.
Review final details at checkout.
Looking to place a bulk order? SUBMIT DETAILS
Delivery Options
Please enter pincode to check delivery time.
*COD & Shipping Charges may apply on certain items.
Review final details at checkout.
About The Book
Description
Author
La botanica è una disciplina di base per le specialità farmaceutiche e agricole. La botanica è una disciplina di base per le specializzazioni farmaceutiche e agricole che determina soprattutto la selezione dei materiali di studio e la verifica indipendente delle proprie conoscenze. Questo libro di testo presta attenzione alla citologia all'istologia all'anatomia alla morfologia e alla fisiologia delle piante. Il libro di testo prevede un approccio all'apprendimento centrato sulla persona basato su una varietà di contenuti e forme del processo educativo che prevede lo sviluppo di ogni studente secondo compiti a più livelli. Ogni studente ha il proprio livello di interesse e di capacità in questa disciplina. Questa formazione aiuta tutti a costruire il successo nel raggiungere la padronanza della botanica a prevedere i risultati le competenze e le capacità di applicare le conoscenze acquisite. Un approccio centrato sulla persona incoraggia la crescita l'auto-miglioramento e il passaggio a un livello superiore di acquisizione delle conoscenze.Una delle forme di formazione per lo sviluppo dell'attività cognitiva dell'intero processo di apprendimento è rappresentata dai compiti multilivello.
Details
ISBN 13
9786208554989
Publication Date
-15-01-2025
Pages
-240
Weight
-331 grams
Dimensions
-152x229x13.85 mm